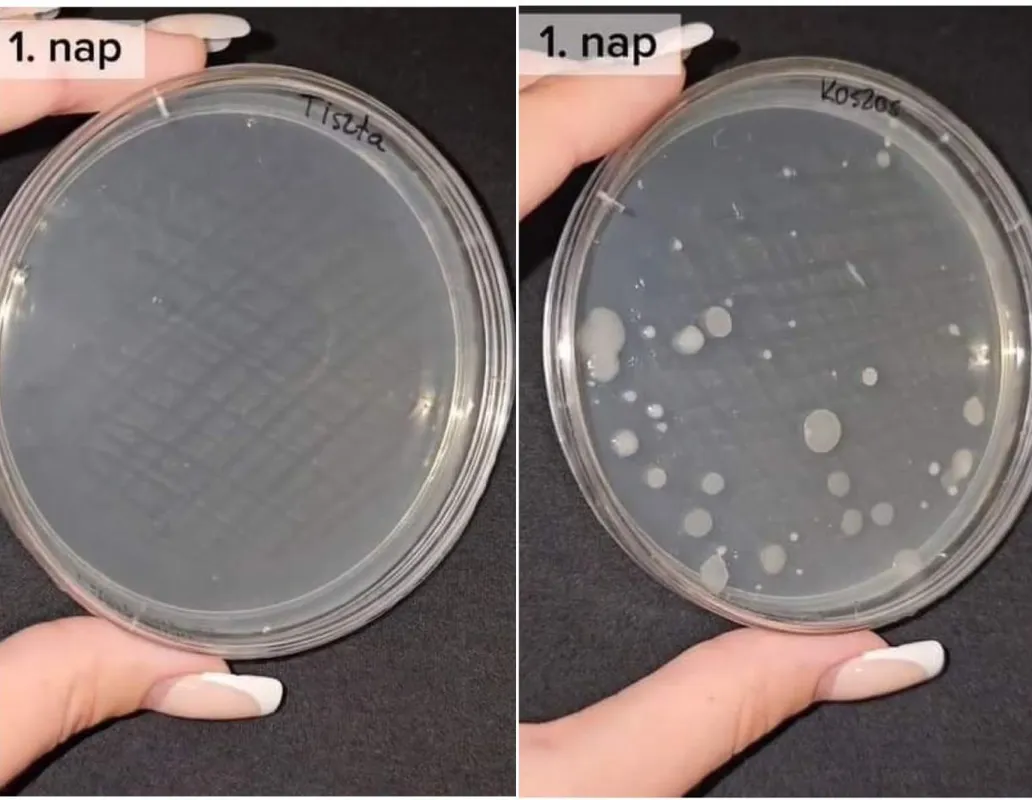
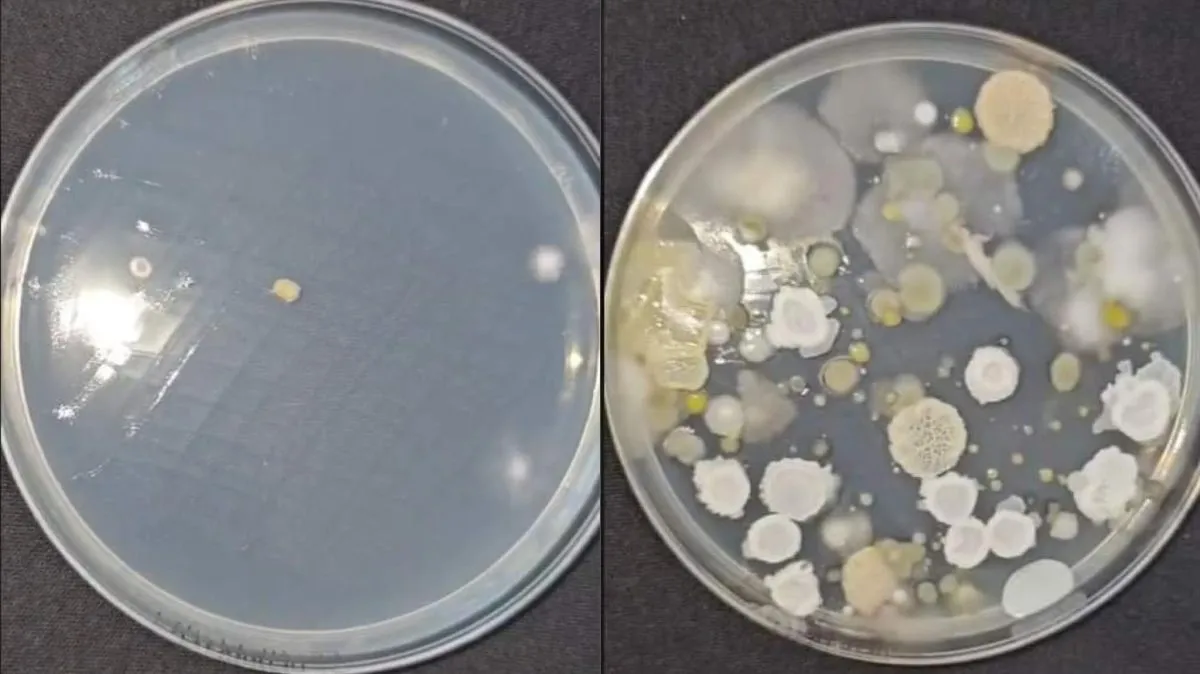

Letesztelte a szakember: Ennyi baci van a telefonodon – Videó
Gyuris Rita növényorvos letesztelte, hogy mennyi baktérium és gomba található egy telefon kijelzőjén. Mutatjuk az eredményt.
Gyuris Rita növényorvos mindenféle érdekes tárgyról vesz mintát plantprotecting nevű TikTok-csatornáján, majd kitenyészti azokat. Százhetvenezres követőtáborának tesztelt már például villamost, vécét, most pedig azt mutatta meg nézőinek, mennyi baktérium és kórokozó található egy telefon kijelzőjén.

A legtöbb ember, amikor már azt látja, hogy koszos a telefonja kijelzője, a pólójába törli meg azt. De vajon ez elég hatásos tisztítás? Erre a kérdésre kereste legújabb videójában a választ Rita. Azonnal elő is kapta az ujjlenyomatokkal teli telefonját, amiről egyszer használatos steril mintavevő pálcával vett mintát, amit táptalajra helyezett.
A táptalaj az egy olyan közeg, ahol fel tudnak szaporodni ezek a mikroorganizmusok
– magyarázza a videóban.
Ezután alaposan megtörölgette a pólójában, majd arról is mintát vett.
"Tényleg ügyeltem rá, hogy ne maradjanak rajta foltok, ujjlenyomatok és látszólag elég szép is lett az eredmény" – folytatja.
Jöjjenek az eredmények
Az első napon a pólóban megtisztított mintán semmilyen kórokozó nem látható, viszont a koszos kijelzőről vett mintán már 24 óra után megfigyelhető, hogy baktériumok kezdtek el felnőni.
Második napra a koszos kijelzőről vett mintán már megjelentek a gombák is, míg a pólóban megtörölt kijelzőről vett minta ugyanúgy kórokozómentes maradt. A harmadik napon végül azon is megjelent egy gombatelep és egy baktériumkolónia. Azonban még így is hatalmas a különbség a megtisztított és a koszos kijelző között.
Ezért is olyan fontos, hogy napi rendszerességgel tisztítsuk le a telefonunkat, ugyanis ezek a gombák és baktériumok okozhatják a különböző pattanásokat és bőrbetegségeket az arcon.






